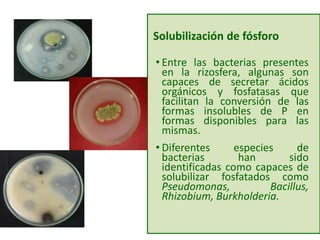
Solubilización de fósforo
• Entre las bacterias presentes
en la rizosfera, algunas son
capaces de secretar ácidos
orgánicos y fosfatasas que
facilitan la conversión de las
formas insolubles de P en
formas disponibles para las
mismas.
• Diferentes especies de
bacterias han sido
identificadas como capaces de
solubilizar fosfatados como
Pseudomonas, Bacillus,
Rhizobium, Burkholderia.
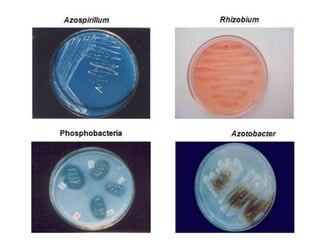

El documento describe los microorganismos benéficos en el suelo y su importancia para la calidad y fertilidad del suelo. Los microorganismos juegan un papel clave en los ciclos de nutrientes, la regulación de la materia orgánica, la fijación de carbono, y mejoran la salud y crecimiento de las plantas. Ejemplos específicos incluyen la fijación simbiótica de nitrógeno, la simbiosis micorrícica, y bacterias promotoras del crecimiento vegetal como Azospirillum que producen